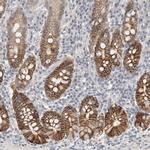
HCN3 Antibody in Immunohistochemistry (Paraffin) (IHC (P))

Search
Invitrogen
HCN3 Polyclonal Antibody
{{$productOrderCtrl.translations['antibody.pdp.commerceCard.promotion.promotions']}}
{{$productOrderCtrl.translations['antibody.pdp.commerceCard.promotion.viewpromo']}}
{{$productOrderCtrl.translations['antibody.pdp.commerceCard.promotion.promocode']}}: {{promo.promoCode}} {{promo.promoTitle}} {{promo.promoDescription}}. {{$productOrderCtrl.translations['antibody.pdp.commerceCard.promotion.learnmore']}}
产品信息
PA5-82925
种属反应
宿主/亚型
分类
类型
抗原
偶联物
形式
浓度
规格
纯化类型
保存液
内含物
保存条件
运输条件
RRID
产品详细信息
Immunogen sequence: LPLSPDSPAT LLARSAWRSA GSPASPLVPV RAGPWASTSR LPAPPARTLH ASLSRAGRSQ VSLLGPPPGG GGRRLGPRGR PLSASQPSLP QRATGDGSPG RKGSGSERLP PSGLLAKPPR TAQPPRPPVP EPATPRGLQL S
Highest antigen sequence indentity to the following orthologs: Mouse - 88%, Rat - 88%.
靶标信息
HCN3 is a member of the family of hyperpolarization-activated and cyclic-nucleotide-gated (HCN) channels. HCN currents have been linked to pacemaker activity in the heart and brain, resting potential control, as well as neuronal plasticity. HCN3 has been detected in the brain, but with less expression than other HCN channels.
仅用于科研。不用于诊断过程。未经明确授权不得转售。
篇参考文献 (0)
生物信息学
蛋白别名: MGC131493; potassium channel; Potassium/sodium hyperpolarization-activated cyclic nucleotide-gated channel 3; unnamed protein product
基因别名: HCN3; KIAA1535
UniProt ID: (Human) Q9P1Z3
Entrez Gene ID: (Human) 57657